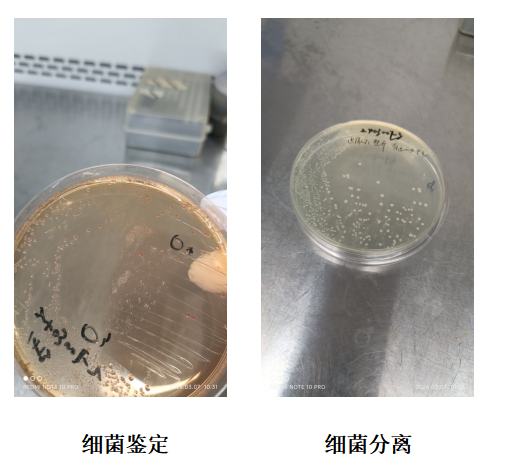
image.png
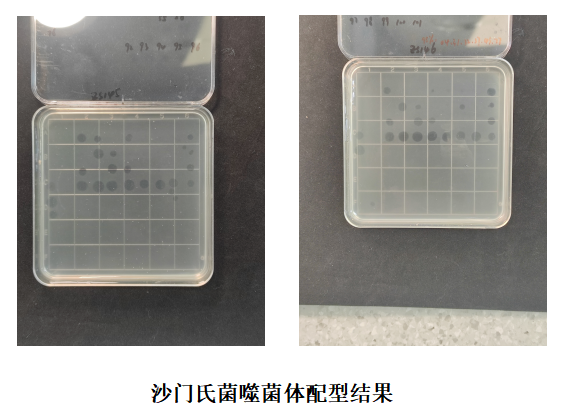
image.png

发布时间:2024-05-23 09:30:05 浏览次数:576次

禽沙门氏菌病是由沙门氏菌属中多种细菌引起的疾病的总称,根据病原、临床症状和发病日龄主要分为鸡白痢、鸡伤寒和鸡副伤寒。病鸡和带菌鸡为本病的主要传染源,通过粪便、污染水源、饲料和环境也可传播,主要经消化道和呼吸道感染,也可经卵垂直传播,发病无季节性,多雨潮湿季节多发。一般呈散发性或地方流行性。
1.临床情况:
2024年03月湖南株洲某肉鸡养殖场,11日龄4万羽肉雏鸡突然出现大量急性死亡现象,死亡率达10%。使用恩诺沙星无明显效果,取弱雏和死亡雏鸡发现肝脏发绿或肝脏表面有出血,与本公司技术人员交流后推测为沙门氏菌感染,如下图:

2.检测诊断:
养殖场紧急采样,并送到公司进行细菌学检测,发现平板细菌较纯,可以判定其为致病菌,经选择性平板和PCR鉴定确定为沙门氏菌,病原与临床症状一致,运动性、鸟氨酸和赖氨酸及PCR血清型鉴定为鸡白痢沙门氏菌,平板图片如下:
3.噬菌体配型
根据细菌鉴定结果,挑取部分单菌落进行沙门氏菌噬菌体配型,发现噬菌体库中有大量噬菌体可以对其进行裂解,根据噬菌体的裂解效果和噬菌体之间的互补性选择最优噬菌体组方配制产品,噬菌体配型结果和噬菌体裂解谱如下图:

4.结果
根据检测结果和噬菌体配型结果,配制微噬沙克产品,按照200ml/1万羽进行饮水使用,连续使用3天,现场表现为雏鸡死亡消失,取得非常好的效果,客户回复效果图如下:

下一条:黄鳝养殖应用案例-微噬胞克

服务热线(期待您的来电):

地址:湖北省武汉市江夏区郑店街道光谷南大健康产业园30号

邮箱:HBZW_Chenzaiwei@163.com
扫一扫关注我们
